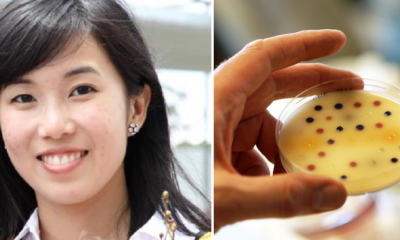
25-year old Malaysian Grad student that may have found a resolution to the superbug issue - World Of Buzz 4
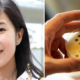
25-year old Malaysian Grad student that may have found a resolution to the superbug issue - World Of Buzz 4

A parents’ love is truly one thing we all forget to appreciate. Our parents love us so dearly that often times they sacrifice so many things...


A cat casually joined a class in International Islamic University Malaysia (IIUM) a few days ago and the feline friend quickly earned its spot on the...


A mother is one of the greatest beings on Earth. They struggle through nine tough months to give life to you, slave away for so many...

For most of us layman, it’s probably one of those rare times we hear of the superbug in passing. A superbug is basically a bacteria that...


Living with a stranger can be a stretch for anyone. Only God knows the ugly squabbles provoked by unforgiving roommates. Especially for university students, we all...


In a recent Facebook post, a user named Ronn Conggek posted a shocking video of a pedestrian being knocked down HARD by a motorcyclist who ran a...


Recently, UiTM Samarahan student named Syahrizzal Arfandy wrote an open letter addressed to college mate Norzam Aminudin on September 7, 2016. The open letter was...


During our school days, we have all either been a bully, bully victim, or witness of bullying cases. Back then, bullying was such a rampant and...


Almost as seamless as ordering takeaway from FoodPanda, WeChat is now the it mobile application for, how do I put this subtly… PROSTITUTION. Shockingly, most users...


Photo for illustration purposes only – Credit: forum.sgclub There is the amazing, the funny, but also the very weird part of the internet. Used panties are being sold...


Credit: shanghaiist.com If you thought your dorm rooms in uni was bad, wait till you get a load of this! Pun totally intended. A middle school in...


Image source: AllSingaporeStuff & aspirantsg Daniel Chow, a teacher recently shared his thoughts on Pokemon and how it relates to students, especially young ones. His post has opened...


Laws of a country are put in place to ensure and maintain order and safety within the nation. But sometimes those laws aren’t necessarily followed, not even...


Credit: kl.coconuts.co A student in Kelantan was hospitalised after she was allegedly slapped by her teacher for shaving her eyebrows. The Star Online reported that Nursyahida Zulkifli...


Things are looking grim for cab drivers as they once again make headlines for the wrong reasons. A female international student suffered from a broken spine...


Disclaimer: Image used is for illustration purposes only So apparently tertiary education is not as great as everyone thought as studies show that university graduates have an increased...